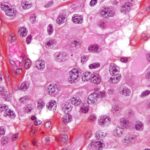
Oligodendroglioma1 high mag e1422819141813 أسباب الإصابة بمرض السرطان مجلة نقطة العلمية

هل سبق أن جربت كوب شاي الإفطار أو قهوة الصباح بملعقة العسل بدلاً من السكر؟
ليس حتى الآن؟ ربما ستحب أن تجرب ذلك بعد أن تقرأ هذا المقال.
العسل، هذا السائل الجميل الذي يصنعه النحل يحتوي على 40% من سكر الفركتوز، أما سكر المائدة فيحتوي على 50% منه، بينما يحتوي محلّي سائل الفركتوز الذي يستخدم في معظم الحلويات والمشروبات الغازية التي تتناولها على حوالي 40-90% من الفركتوز، وهذه نسبة عالية جداً، خاصة إذا عرفت أن هذا السكر تم ربطه بأمراض الكبد والتمثيل الغذائي.
ولهذا فكونه يحتوي على النسبة الأقل من هذا النوع من السكر فهذا يجعله متفوقاً عليهم في هذه النقطة.
وليس هذا فقط، بل إن العسل يحتوي على مواد مغذية عظيمة الفائدة، إذ أن أفضل شئ فيه صحياً هي المواد المضادة للأكسدة، والتي تحمي خلاياك من الدمار، فقد ربطته الأبحاث الطبية بتقليل خطر التعرض لأمراض القلب لهذا السبب.
كما أنه يحتوي على الأحماض الأمينية والفيتامينات والمعادن مثل الثيامين والريبوفلافين والبيرودوسكين وفيتامين أ والنياسين وحمض البانثويك وفيتامين إي وفيتامين سي، وتختلف نسب هذه المواد تبعاً لاختلاف النبات الذي جاء هذا العسل منه.
هل رأيت قبل ذلك أحداً يضع العسل على حرق في يده، أو جربت ذلك بنفسك؟
إن ذلك له معنى، فهو مفيد فعلاً لشفاء الحروق والجروح.
هذا يجلب تساؤلاً مهماً، ما تأثيره على مرضى السكري؟ وهل علينا الانتباه لشيء معين عند استخدامه؟
والإجابة على هذا كانت في بحث أجري على 48 مريضاً بالسكري، ووجدوا أنهم أظهروا انخفاضاً في الوزن والكوليسترول السيء، لكن في ذات الوقت كان مستوى السكر في دمهم مرتفعاً، وكانت مستوى التحكم بالسكر سيئاً.
كما أنه عليك ألا تنسى أنه سكر في النهاية، تحتوي الملعقة الصغيرة منه على 21 كالوري مقارنة بـ16 كالوري في سكر المائدة، لذلك ينصح الخبراء بعدم الإكثار عن 6 ملاعق شاي صغيرة للنساء ولا يزيد عن 9 للرجال.
كما ينصح بعدم إعطائه لطفل أقل من سنة، لاحتوائه على نسبة ضئيلة من بكتيريا البوتيولينيوم مسبباً أثراً سمياً نادر جداً لكنه ممكن، وهو آمن عامة.